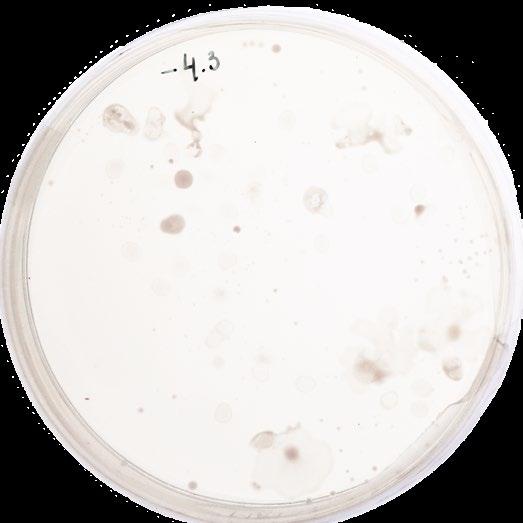
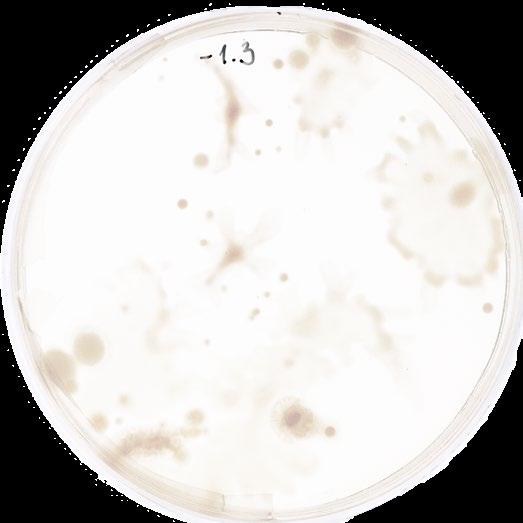
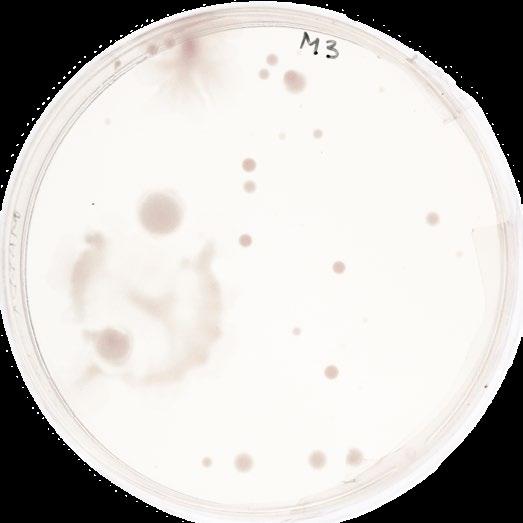
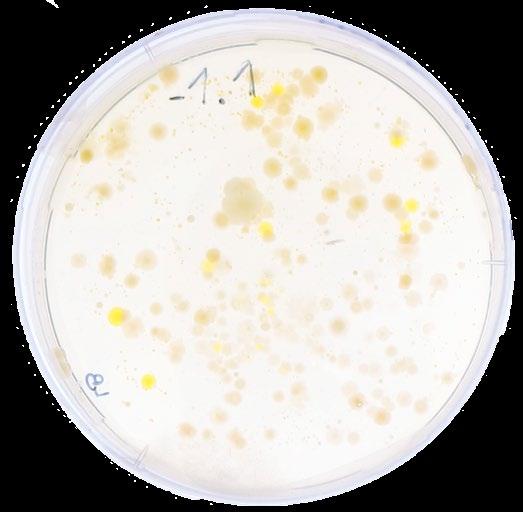
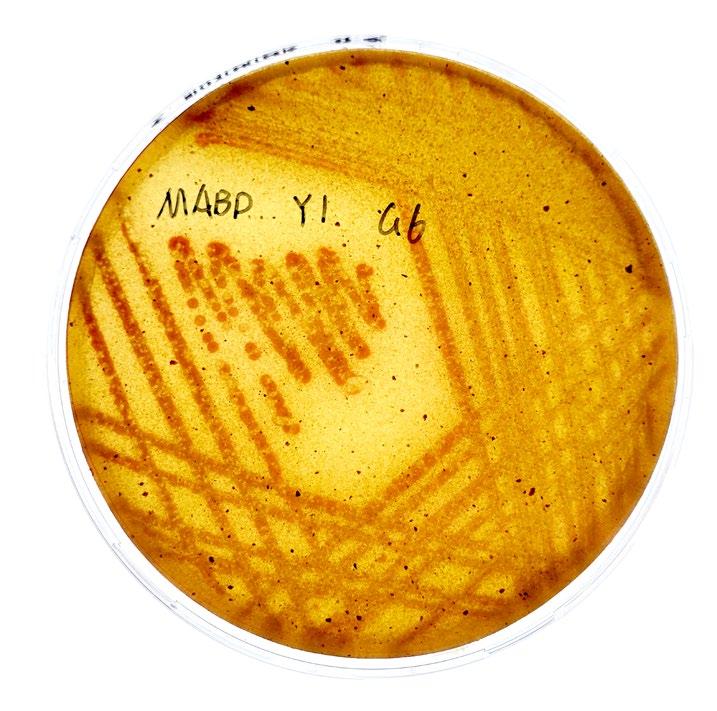
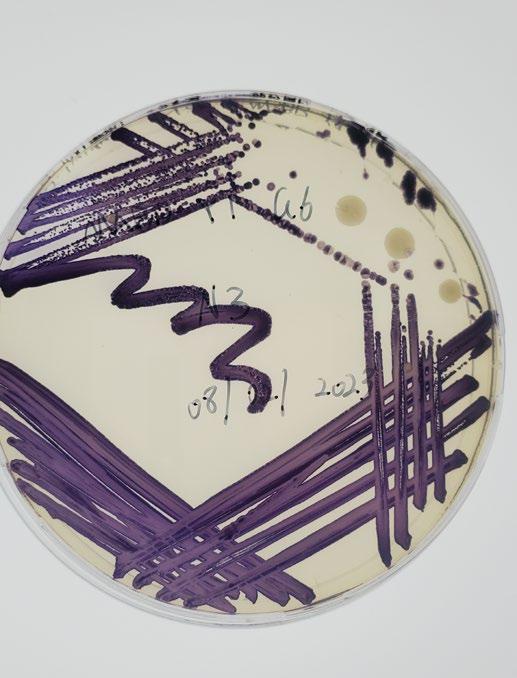

Unit 1: Seed
 Shijia Huang
Shijia Huang
Submitted in partial fulfilment of the requirements for the degree of Masters in Biodesign
2022/2023 Central Saint Martins UAL
Tutors: Nancy Diniz – Course Leader MA Biodesign, CSM
Alice Taylor – Lecturer of Biology and Living Systems MA Biodesign, CSM
Jon Flint, Lecturer in Design and Fabrication, MA Biodesign, CSM
Thora Arnardottir, Associate Lecturer Interdisciplinary Design Studios, MA Biodesign, CSM UAL
Alejandro Luna – Associate Lecturer in Sustainability and Innovation, MA Biodesign, CSM UAL
Lorraine Archer – Associate Lecturer Environmental Science, MA Biodesign CSM
Anouk Zeeuw van der Laan - Associate Lecturer in Sustainability and Circular Economy MABD CSM
Lucrezia Alessandroni - Biodesigner, Graduate Teaching Assistant MABD CSM
Paula Corsini - Specialist Grow Lab Technician CSM
Shem Johnson - Specialist Grow Lab Technician CSM
Table of Contents 01 Living Matter Mapping Ecosystems Green Planet Feral Metropolis 02 Living Minerals Swarovski × MA Biodesign 03 Field Trip Documentation 04 Grow Lab Experiments 05 References 01 07 11 19 29 33 35
Mapping Ecosystems

01
well-lit + bare wood (exposed by damage)



= mosses, liverworts, lichens, algae and micro-fungi



age of the tree



= amount of epiphytic species








after life
Hampstead Heath Park
‘Ancient trees are precious. there is little else on earth that plays host to such a richt community of life within a single organism.’

 Sir David Attenborough
Sir David Attenborough
Softened up wood allows invertebrates to feed / decompose the wood further

In modern western culture, when a human body dies, it usualy gets taken out of the greater ecosystem. Thus, breaking its interconnectedness with the world around it. Worryingly this approach has crept into the way we manage forests. however, When tree die, but are allowed to stay a part of their environment, they shift their role in the emerging ecosystem - One that creates a vital and critical environment for plantae, animals, fungi, and other microorganisms.

They all thrive in a tree’s afterlife
Saproxylic fungi

UNIT 1 SEED 2
Growth (300 years) Rest (300 years) Decline (300 years) Decomposition / softening up of the
Healthy hummus layer
wood
Decaying wood
Mapping Ecosystem
40% of woodland wildlife depends on the dead trees Living tree 5% living cells per volume Dead tree 40% living cells per volume
Hampstead Heath
Ecosystem

UNIT 1 SEED 3
Mapping Ecosystem
Ways of Seeing
Different ways of seeing from different animals on site
Ladybug Vision
Ladybugs have compound eyes, however, they are colour blind, so that can only see in shades of black, white and grey.
Ant VisionAntshave compound eyeswith many units, called ommatidia.Their worldis blurrier than ours.







Humaneyehas





visiblelight spectrum. These coloursare blue, green,andred.
three typesof conesthat allowustoseethe
Human Vision
ultraviolet spectrum.

Bee Vision Beescanonlysee yellow, green, blue,and coloursonthe
Bird Vision BirdscanseeUV light. Someof themcan evensee magneticfields




Dog Vision
Dogs have dichromatic vision, possessing only two types of cones . They can only discern blue and yellow.

UNIT 1 SEED 4
Samples observation and Lab Experiments




















UNIT 1 SEED Mapping Ecosystem Site 01 Original Inoculum 1:10 1:1000 1:1,000,000 1:1,000,000 1:1,000,000 1:1000 1:1000 1:10 1:10 Site 02 Original Inoculum Site 03 Original Inoculum +100 µL +100 µL +100 µL +100 µL +100 µL +100 µL +100 µL +100 µL +100 µL Serial Dilution SOIL SAMPLES - DAY 5 Afterlife on a plate
Mapping Ecosystem

Prediction
2012 2008 2019 Present
Declining oak tree. There was no regeneration present.
Regeneration started, young trees began to grow around it.

Regeneration developing through the years. More and more trees and bushes appeared around the dead oak tree.

2030?
Regeneration is taking over the place. The small plants gradually replace the dead one, using the nutrients that the dead oak no longer need.
2013 2016 2050?
The tree’s roots were damaged when the adjacent path was installed. It was crown reduced in 2013 due to a significant lean and the presence of a hollowing stem and wood decay fungi Fistulina hepatica.

Present
In 2016 it was noticed that this tree had a cracked buttress root, and eventually fell the following day during calm conditions.
This fallen oak tree has been retained as it provides a valuable saproxylic resource. A new ecosystem emerges when it died.
The new ecosystem gradually take over the fallen oak, using the nutrients that the oak tree build itself during its lifetime.










Present
Due to some unknown reasons, a branch of the tree suddenly fallen down.
Leaves on the fallen branch began to rotten. Moss stared to grew on it.
2030?
Moss and fungi take over the dead branch. Small plants growing along side. A competition takes place. Who will win in the end?
UNIT 1 SEED 6
02 Green Planet

Fruits and Seeds
Anatomy
Plum Drupe Banana Berry



Pomegranate Berry




Cucumber Pepo


Exocarp (Taste & Scent)
Exocarp (Scent)
Endocarp Endocarp
Mesocarp (Taste & Scent)
Mesocarp (Scent)
Aborted seed
Exocarp
Mesocarp
Endocarp (white)
Arils
Exocarp
Arils
Endocarp Seed coat

Seed
Arils Seed Seed coat
Mesocarp Seed

NO Endocarp

UNIT 1 SEED 8
Green Planet
Plants Experiments and Observation
Leaf cutting propagation




Hormonal control in meristems
Hormonal Control in seeds
Result:
Mose of the leaves are starting to wither and turn yellow, only the succulent plant remains green.

MS plant growing media + 1.0 mg/l GA3 hormone
Result:
MS plant growing media + 0.25 IAA plant hormone
MS plant growing media + 1.0 mg/l GA3 hormone

MS plant growing media + 0.25 IAA plant hormone


The edges of leaves are darkening, there is no significant difference between two hormone media.
Result: Seeds in both vials have germinated.





UNIT 1 SEED 9
Green Planet











UNIT 1 SEED 10
Green Planet Gathering Microalgae Samples Scaling up Microalgae TLC Pigment Separation
Microalgae Workshop
03 Feral Metropolis

Re:Rewilding
Hollow Pond, Leytonstone Desertification


Context:
2022 Heatwave

Summer wildfire in London

Desertification is a type of land degradation in drylands. We were given this brief to challenge ourselves to find a type of solution that would somewhat solve the problem of desertification. We had a series of experiments conducted focused on desertification. We’ve explained the process of each section of our project “Re:Rewilding”.
Location
Unburnt area with trees and green grass
Prediction
Due to global warming, the temperature is predicted to increase from 40 °C-50 °C and by 2050 Hollow pond park might turn into a semi-arid desert.


12
Feral Metropolis
Burnt area
Feral Metropolis
Problems
Nutrient analysis
Soil samples collected from burnt and unburnt area


Soil Layers
Surface layers
Grass / Moss,ferns / Algae / Roots
Organic debris, partly decomposed (O horizons)
Top soil
Carbon rich soil (3cm)


Organic debris, partly decomposed (O horizons)
PH - Acidic (3.5)
PH - Acidic (3.5)

Nitrates - very low
Nitrates - low
Phosphates - very low
Phosphates - low
Potassium - very low

Potassium - low
Carbon - High
Carbon - Medium
Subsoil
Dry soil

Mineral particles mixed with organic material (A horizons)

Parent material
Gravel bed
Compounds draining from above accumulate (B horizons)

Partlyweathered rock (C horizon)
Bedrock (R horizon)
UNIT 1 SEED
Burnt area
Unburnt area
Problems
Our soil analysis consisting of nutrient analysis of nitrates, phosphates, potassium and other testes consisting of PH analysis, carbon content analaysis, silica content and funnel test. For other soil biodiversity coupled with our observation on site helped us understand the reason behind the lack of biodiversity in the area as well as the complex causal relationship of the various factors that lead to desertification. While the unburnt area had biodiversity levels building up starting from algae, moss, ferns and grasses sharing the same surface , the burnt area lacked that diversity due to the morphology of the soil that consisted of mostly silica and carbon that only allowed grasses to grow, which are more susceptible to wildfires and clearly demonstrated loss of biodiversity pointing towards desertification.
Reduced carbon sequestration into above and below grounds carbon reserves

Hollow Pond


Desertification
Accelerated by Global warming
Decreased plant and soil organism species diversity agravated by soil morphology


On-site Experiments











Increase in extreme events like droughts and wildfires
Reduced primary production and nutrient cycle
Reduced soil conservation
Soil erosion
Climate Change
Reduced carbon reserves and increased CO2 emis
Loss of nutrients and soil moisture

Reduced structural diversity of vegetation cover and diversity of microbial species in soil crust
Biodiversity Loss
Increase and reduction in species abundences


Change in community structure and diversity

UNIT 1 SEED 14
Feral Metropolis
Hybrid cacti-machine system
The role of the machine system is to create and sustain an ideal environment consisting of replinishing nutrients and moisture in the soil before and after the event which involves extensive planting of bio-hybrid plants. These machines are a hybrid between an actual cacti and an artifical machines. They mimic the functionary processes such as entrapment, storage and distribution of moisture and nutrients in cacti and uses membrane sacks, vascular networks developed from the cacti tissues those are connected with spohisticated artifical machines with its own sensors and intellect. They form a complex symbiotic relationship with each other and the environment complex root like network like real organisms in any given environment.
The system consists of 4 different cacti-hybrid pods that works in a system together in a root like network spread accross the landscape. Each pod has specific role to play where the pod trapping, storing and distributing water is the central and a set radius where it impacts. Connected to each other with a root like neural network fitted with the sensor they work in a symbiotic harmony that studies the needs of soil and each others needs and perform accordingly by distributing the nutrients throughout the landscape. All pods mimic the vascular system of cacti where one tube transports water from the tank to the culture pods and the other transports cultured algae from the culture pods to the soil.
 Feral Metropolis
Feral Metropolis
Feral Metropolis
Hybrid cacti-machine system
Sections
Water absorption Water storage tank
Water absorption and transfer through roots

Stomata plugs for air exchanging.

Moss and lichen culture room
Moss and lichen culture room
Water pump
Green Algae Injection Tube



Culturing Cells
Sterm for water pumping
Water absorption through trichome
Air changing through stomata
Algae spreading
Water pump
Cyanobacteria Injection Tube
Culturing Cells
Sterm for water pumping
Water absorption through trichome



Air changing through stomata
Cyanobacteria spreading
Water pump
UNIT 1 SEED 17
Air exchange Liquid Flow Direction Bio mass Water absortion
Hybrid cacti-machine system
 Feral Metropolis
Feral Metropolis
04
Living Minerals
Swarovski X MA Biodesign

Project DNA

Classic Romance
Stylish taste
Elegant style
Can we bring the living organisms into crystal coloration process and have a positive impact on our planet?

Brand color vision: To provide color-matched gemstones that are readyto-set to companies and private customers around the world.
Sustainability
To add sparkle in people’s everyday life.
Sustainable goals: Six strategies
Greenhous Gas Emissions

Melting glacier the Alps
Global warming
Biodiversity change
Use color to represent the color change of biodiversity around the Alps

20 Living Minerals
Living Minerals

Swarovski and Astrian Alps

Location
Daniel Swarovski and his partners find the ideal location for their company in Wattens in the Austrian Alps.
Climate Change
Satellite image shows that from 2021 to 2022, there are a great amount of glacier mass had disappeared because of global warming



Wattens
Swarovski birthplace
Natural Barrier
The Alps provide seclusion, safe from imitation
Water Source
The water from the Alps power the machines in Wattens
The consequences of global warming
Greener Mountain
Global warming makes the Alps greener and greener
Vicious circle
Greener mountains reflect less sunlight lead to further warming, and further shrinkage of snow cover
Migrating
Species migrating upwards
Biodiversity Loss
Specialised species in Alps lose their advantage and outcompeted
UNIT 1 SEED 21
Wattens
Alps Mountains
2021 2022
Glaciers near Zermatt in July 2021 – a ‘normal’ year. Copernicus Sentinel / European Space Agency - ESA, CC BY-NC
The same glaciers in July 2022. Copernicus Sentinel / European Space Agency - ESA, CC BY-NC
Swarovski and Colors
Coloration process for SWAROVSKI crystals



















































































Color of Swarovski
Components Collection
New opportunities of Color
Color extracted from living organisms




















































Raw materials






















































































Melting Adding metal oxides in melting process to change crystal color




























































Finishing

Using PVD (Physical vapor deposition) to create a coating








































































Cutting

UNIT 1 SEED Living Minerals P—34.35 SWAROVSKI COMPONENTS COLLECTION
Living Minerals
Lab Experiments


Living Bacteria




Bacterial medium on crystals Bacteria grow around crystals


UNIT 1 SEED
Bacterial culture on Petri dish
Bacterial culture on Petri dish (Day 3)
Living Minerals
Lab Experiments

Pigment Extraction
Bacterial extracted pigments



Pigments extraction

UNIT 1 SEED 24
Bacterial culture on plates
Lab Experiments







Coating of Crystal








UNIT 1 SEED Living Minerals
Plan A: Put the crystal into the bacterial petri dish and cultivate it together.
Plan B: Cover the surface of the crystal with agar, then incubate the bacterial pigment.
Plan C: Coating made from agar
Plan D: Coating made from agar with an Alpine shaped backing
Shaping cellulose Dyeing of cellulosic fibres
Cellulose extraction from pineapple
Plan D: Using dyed cellulose to creating the crystal back-
Living Minerals




Final Prototype

Diagrams
Moulding / 3D Glass Printing
Bacterial pigments
Plugging screw Rings






UNIT 1 SEED 27
Final Prototype Living Minerals

UNIT 1 SEED 28
Materials Melting Moulding Shipping
Culturing Harvesting Color Mixing Injecting Finalizing Pick up Refill Change Color Extracting
Crystals 3D Glass Printing
Minerals
Raw
Bacteria
Pigments
Living
System Development
customer Factory Local store Biolab Customer
Swarovski Biolab An interactive experience for
05 Field Trip Documentation

Hampstead Heath


Dead Trees and After lifes










UNIT 1 SEED 30 Field Trip Documentation
Hampstead Heath
Sample Collections
Sample Preparation


















UNIT 1 SEED 31 Field Trip Documentation
Margate: Haeckels
Seaweeding







Lab - Extractions







UNIT 1 SEED 32 Field Trip Documentation
Seaweeds under microscope
06 Grow Lab Experiments

Pigments Extraction

Bacteria Pigments



Protocol:
S. marcescens pigment production medium
Yeast Extract: 10g
Dextrose: 1.8g
K2HPO4: 0.1025g
KH2PO4: 0.068g
Calcium Chloride: 11g
Sodium Chloride: 11g
Agar (plate culture): 15g
Distilled water 1000.0 ml
J. lividum pigment production medium
Yeast Extract: 2g
Meat Peptone: 5g
Glucose: 10g
Sodium Chloride: 5g
Agar (plate culture): 15g





Distilled water 1000.0 ml

UNIT 1 SEED 34 Grow Lab Experiments
Plates Culture Bacteria Harvest Bacteria Culture Medium Making Pigment Extraction Pigments
Reference
Water science school (no date) Water Science School | U.S. Geological Survey. Available at: https://www.usgs.gov/special-topics/water-science-school (Accessed: December 6, 2022).
Wilkinson, C. (2022) What will British weather actually be like in 2050? we asked an expert, Time Out Worldwide. Time Out. Available at: https://www.timeout. com/news/what-will-british-weather-actuallybe-like-in-2050-we-asked-an-expert-071822 (Accessed: December 6, 2022).
(no date) Twitter. Twitter. Available at: https://twitter.com/Syntropynet (Accessed: December 6, 2022).
(no date) YouTube. YouTube. Available at: https://www.youtube.com/ watch?v=WYXvv2Xug-+c&list=PLFbdPS_gmPKEX5b25T-kTrrrow7X2m-+WIU&index=8&t=5413s (Accessed: December 6, 2022).
Paul, V. (no date) Mycorrhizae. Available at: https://www2.nau.edu/~gaud/ bio300/mycorrhizae.htm (Accessed: December 6, 2022).
Benefits of mycorrhizal fungi (no date) Horizon Distributors - Irrigation& Landscape Supply. Available at: https://www.horizononline.com/benefits-of-mycorrhizal-fungi-how-do-mycorrhizal-fungi-benefit-plants/ (Accessed: December 6, 2022).
Jamie (2022) How to get burnt grass green again, The Backyard Pros. Available at: https://thebackyardpros.com/how-

Shijia Huang MA Biodesign Unit 1: Seed Central Saint Martins UAL 2022 - 2023 THANK YOU
 Shijia Huang
Shijia Huang



















 Sir David Attenborough
Sir David Attenborough

Feral Metropolis
Feral Metropolis








 Feral Metropolis
Feral Metropolis